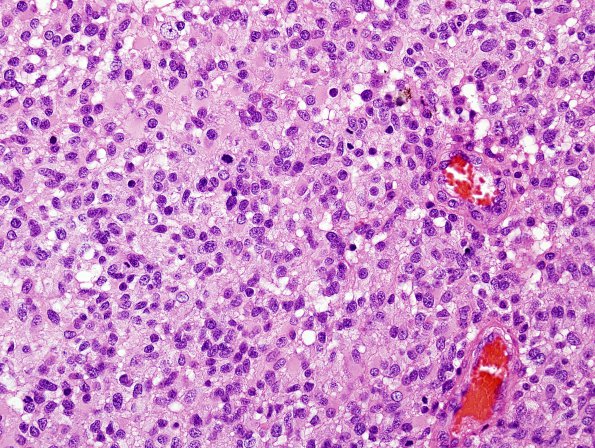
7A4 GBM, small cell features (Case 7) H&E 4.jpg

Table of Contents
Washington University Experience | NEOPLASMS (GLIAL) | Glioblastoma, small cell type | 7A4 GBM, small cell features (Case 7) H&E 4.jpg
Higher magnification of image #7A3 (H&E).---- Ancillary procedures: An immunohistochemical stain for GFAP shows strong positivity in tumor cells. A Ki-67 shows a labeling index of 10.1%. Synaptophysin highlights background cell processes and is weakly positive in scattered neoplastic cells. ---- FISH studies show evidence of EGFR gene amplification and do not show deletion of either 1p or 19q.